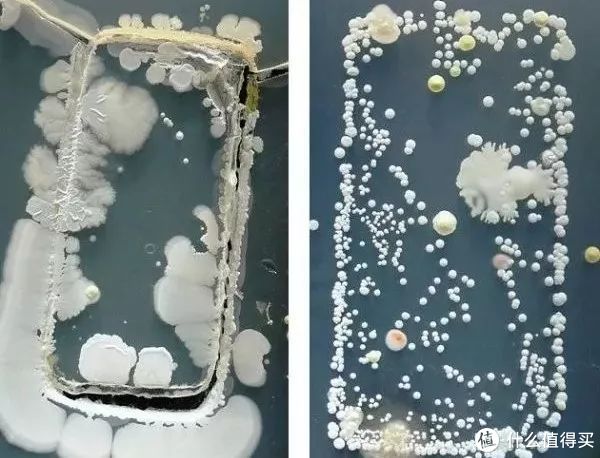

华为充电器使用总结(消毒|充电|兼容)
-
摘要来自:
-
摘要来自:
硬核君 -
摘要来自:2019-08-16
【什么值得买 摘要频道】下列精选内容摘自于《给手机洗个澡,安士宝智能手机无线充电消毒宝评测》的片段:
安士宝无线充电消毒宝的外观就像是手机的包装盒,可以容纳各种尺寸的智能手机,并且三种外观颜色(“梦想蓝”,“炫焰红”,“魅丽橙”),整机尺寸约为22cmX10.8cmX2.8cm(长x宽x高),可轻松置于包包内,方便出门携带。在使用无线充电消毒宝给手机消毒之前,需要在消毒宝盖好盖子后,其UVC-LED紫外线消毒装置才正式开始工作。很多人担心它可能会损害手机,或手机屏幕,其实完全必要!根据来自官网的介绍,消毒宝并不会损坏手机,它只是将紫外线照射在手机上面进行消毒而已。接下来,我们来实际体验一下。

上文也提及到,在使用无线充电消毒宝给手机消毒之前,需要给消毒宝盖好盒盖。而打开/关闭无线充电消毒宝盒盖的方法,只需轻触消毒宝右下角感应开关即可。如下图:

那么手机到底有多脏呢,请看下图(此图片来自网络):
看到这些多“隐藏”的细菌,真的有点可怕。那么接下来我们来尝试着用安士宝智能手机无线充电消毒宝给我们的手机消消毒吧。在无线充电消毒宝盖好盒盖后,UVC-LED紫外线消毒装置正式开始工作,LED灯珠呈现红色灯光。我们先尝试消毒5分钟来看看消毒的效果吧。
消毒时间(5分钟):

消毒前细菌数值(176):

消毒后细菌数值(8):

细菌数值肯定是越低越好,根据实际测试,在5分钟的消毒过程中,细菌量逐渐变低,效果效果还是很不错的。另外根据来自官网的介绍,其可以消灭如细菌,病菌,霉菌孢子,水藻类,鱼类病等“隐形细菌”。

而在无线充电方面,安士宝无线充电消毒宝采用了大线圈扩大感应范围,无需刻意对准或寻找位置,随手一放即可无线充电。可给符合QI标准的安卓手机,苹果手机无线充电。由于消毒宝没有配备充电头,我们需要搭配一个充电头使用,这里推荐使用5-9V,大于或等于2A的充电头。
以下我们对充电方面进行一个简单的小测试,参与的设备为iPhone8 Plus,测试充电头为小米的5V2A适配器,以及苹果的5V1A适配器。


测试结果:
小米5V2A适配器:电压5.3V,电流1.6A
苹果5V1A适配器:电压5.01V,电流1.0A
智慧生活:
安士宝无线充电消毒宝可使用华为智能家居APP,通过其可对手机消毒情况,无线充电状态,进行智能控制,实时了解。实际体验一番下来,还是挺不错的。目前安士宝智能手机无线充电消毒宝APP已经上线,下载APP可体验更多新玩法哦!

总结:

安士宝智能手机无线充电消毒宝是一款集合手机消毒,无线充电二合一的智能产品,采用了医疗级的UVC-LED紫外线消毒技术,可在30分钟内高效消灭细菌,灭菌率达99.99%(根据官网提供的数据),环保且不含汞。而在无线充电方面,兼容了目前市面上主流的智能手机,包括支持QI标准的安卓手机与苹果手机,并且可使用华为智能家居APP实时了解消毒,充电状态。最后就我个人的日常使用体验上来说,这款无线充电消毒宝,在外观颜值上,手机消毒,无线充电上,都有不错的表现。感兴趣的小伙伴们可以去安士宝网站看一下。


